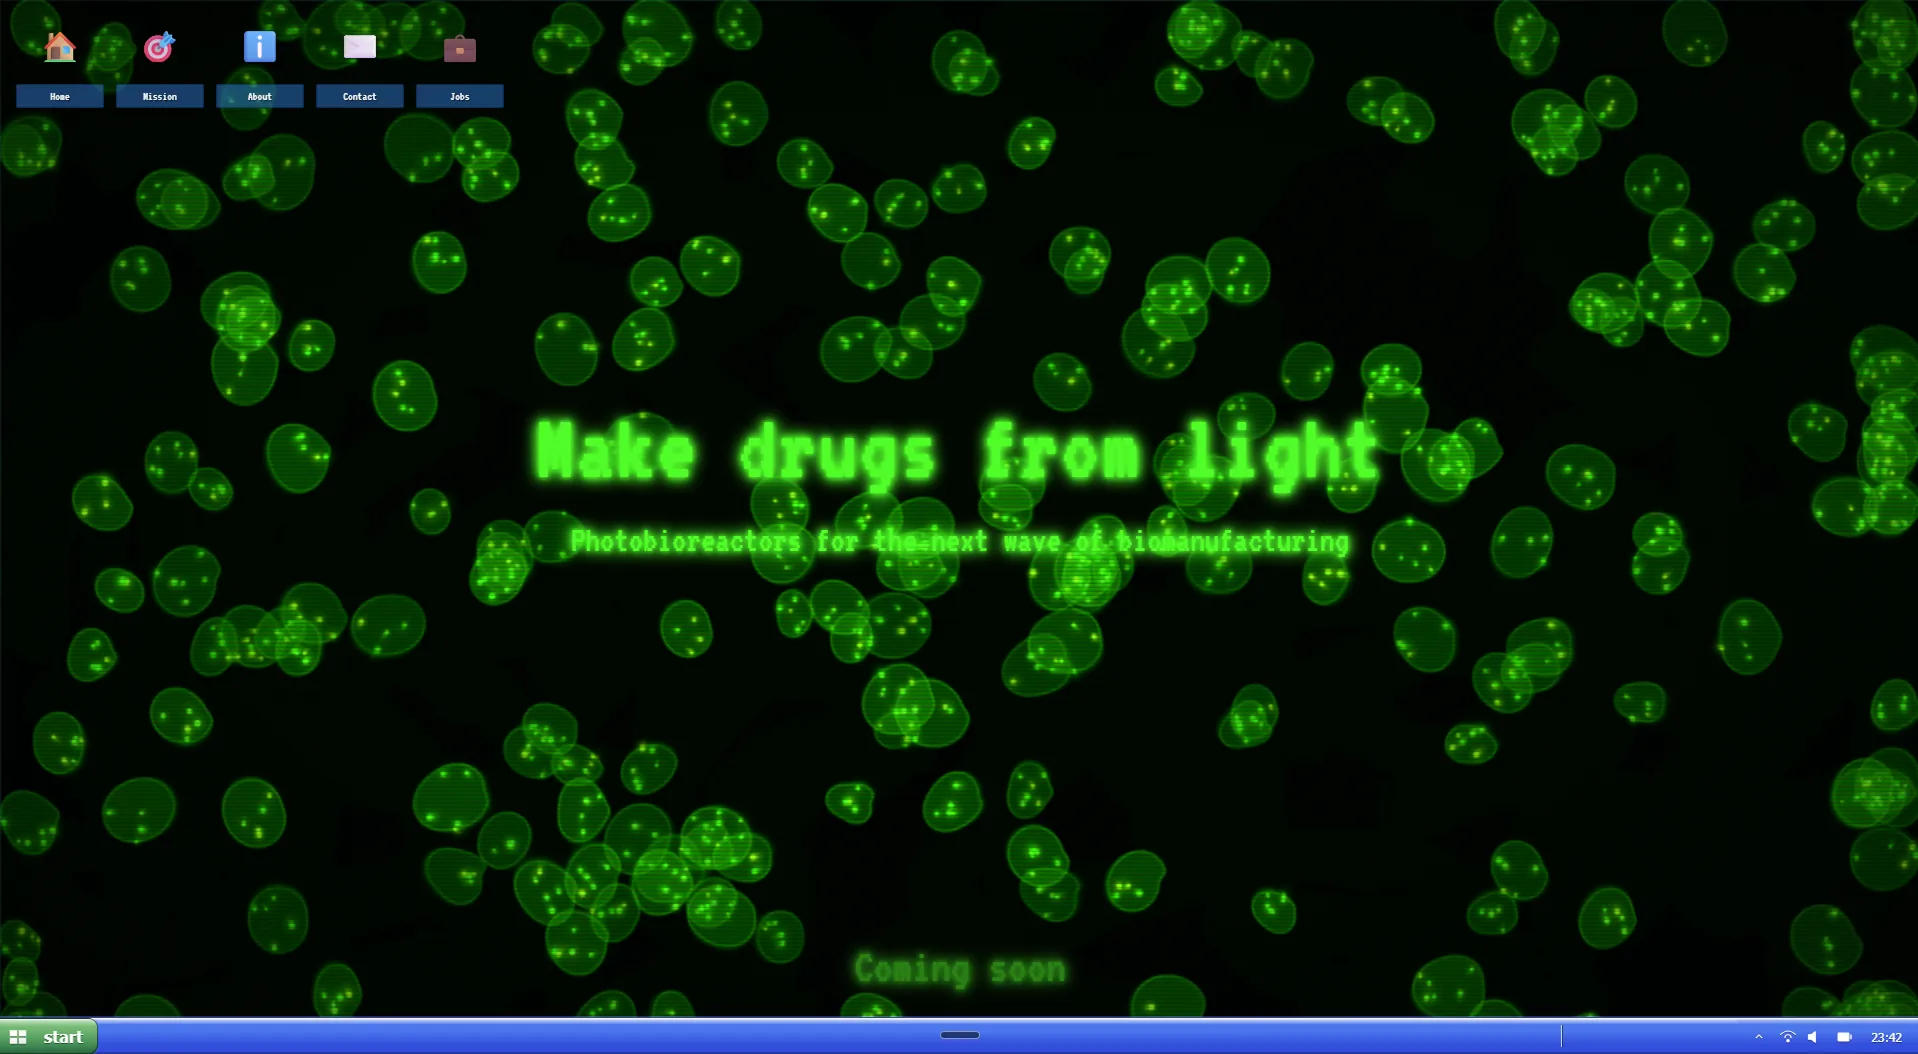
Biotech CMS example

Hello!
Welcome.
Hi, I’m Cuau.
I build hard things with small teams.
I’m a generalist founder / builder who’s spent the last decade moving between hardware, embedded systems, marketplaces, and now AI infrastructure. I’ve been lucky enough to:
- Co-found and ship Sunu, a wearable for blind people, to 40+ countries (YC-backed, raised $1M+).
- Lead Fuddis as CEO through Techstars, helping 300+ food businesses survive COVID with software and logistics.
- Build AI-native products and a CMS/infra layer that hot-loads Django apps with agents and ships in seconds.
I can code, fundraise, sell, design, negotiate with suppliers, and sit with customers in the kitchen at 11 p.m. to understand what’s actually broken. I’m not the smartest person in the room—but I’m very good at getting smart people aligned around a hard problem and shipping until it works.

Why I Do This
My why is simple: I believe technology for good has the power to transform the world, and I want to be part of that.
That belief has quietly guided most of my decisions, even when I didn’t have the words for it—building a wearable to give blind people more independence, helping small restaurants stay alive during COVID, or now obsessing over how AI can turn messy, real-world data into something actually useful.
I’m not interested in building “cool tech” just because it’s possible. I’m interested in building useful tech that touches real people, ideally where hardware, software, and AI collide.
⚡ Snapshot
- 2 VC-backed startups as CEO/CTO (YC + Techstars).
- $2M+ raised across companies, from pre-seed to accelerator funding.
- Shipped hardware + firmware + OS + supply chain for a smartwatch used by blind people in 40+ countries.
- Supported 300+ food businesses across 5 states in Mexico with software + logistics; ~98% monthly retention at peak.
- Built AI-native infra and products (PDF-to-data micro-SaaS, agent-driven CMS) mostly solo, with heavy AI-assisted development.
Builder From First Principles
Before software ate the world, I built things that moved in it. Drones, robots, and autonomous cars taught me that reality is messy and "happy paths" don't exist.
I Like Things That Fly
This 2-meter-wingspan drone is something I built mostly by myself. I designed and assembled the internals, controls, and structure (everything except the handheld controller).
For me, projects like this are not about the drone itself—they’re about learning how systems behave in the real world: vibration, failure modes, sensors lying to you, batteries dying at the worst moment.
These experiences are what later made hardware + AI + infra feel natural instead of scary.



A Robotic Arm (Pre-ChatGPT Era)
During an internship with Intel, I designed and built this robotic arm. I did the CAD, CNC machining, PCB design, and control system myself—before AI tools existed to help. It taught me that if I’m curious enough to grind through the details, I can build full systems end-to-end.

Hacking a Mouse Sensor Into a Race Car
Finished 3rd overall (just behind Chinese teams) in an autonomous racing competition in Texas. I designed the hardware and replaced a traditional encoder with a modified mouse sensor to measure drift and speed. Sometimes the best solutions are a bit weird and held together with curiosity.
Sunu
A Smartwatch for the Blind
At Sunu, I served as co-founder and CTO. We built a wearable that uses ultrasound and haptics to help blind and visually impaired people navigate the world more independently.
I designed all the PCBs myself—from component selection and schematic capture to the final board layout and firmware architecture.
- Built the fusion algorithm for IMU and ultrasonic sensors.
- Wrote the RTOS/scheduler and low-level drivers.
- Designed early enclosures and managed the manufacturing supply chain.
- Demoed live at conferences and engaged directly with users.
We raised $1M+ and shipped to 40+ countries. Looking back, this usually takes millions of dollars and a big team. We did it with me and two other engineers, a lot of mistakes, and a lot of persistence.



PCB Design & Engineering
A look under the hood. I handled the electrical engineering and layout for multiple iterations of the device, optimizing for size, power consumption, and manufacturability.




Prototypes & Other Projects
From manual etchings to 3D printed prototypes and lab testing. I believe in getting hands dirty to figure things out.






Fuddis – Helping Small Restaurants Survive
After Sunu, I stepped into the CEO role at Fuddis. Our journey was… intense. During COVID we pivoted ~5 times: from meal kits, to POS, to a social marketplace.
At our peak we were working with 300+ food businesses across 5 states in Mexico, with around 98% monthly retention. But margins were brutally thin (<5%) and chargebacks erased our profits.
I raised around $1M as CEO, but more importantly I learned how fragile unit economics are and how hard it is for small businesses to adopt new tools. We didn’t become a unicorn, but the experience shaped how I think about distribution, incentives, and survivability.
Falling in Love With AI-Native Building

Turning PDFs Into Structured Data
After Fuddis, I built a micro-SaaS that extracted data from messy PDFs and turned it into CSVs for ERPs using structured outputs and human review loops.
The system processed millions of PDFs with ~98%+ accuracy. I built this solo in about 6 months—AI-assisted development completely changed how I build.
Flowpress → Veloz: An AI-Native CMS
I built an AI-first CMS infrastructure on Django that could hot-load apps into Fly.io machines via CLI. Apps were provisioned in seconds with agents pre-installed. I’d estimate 90% of the code was written with AI assistance, but the architecture and "what should exist?" thinking were mine.

How I Work
- › I’m happiest very early, when the path is unclear and we need to discover it by building.
- › I like to go deep on a problem—talk to users, read research, sketch architectures, and then ship fast.
- › I’m comfortable writing code, debugging hardware, sitting with finance, or pitching investors.
- › I care more about compounding learning than about being “right” on the first try.
What I’m Looking For
- › Build at the intersection of AI, infrastructure, and (ideally) hardware.
- › Work with a small group of very sharp, very kind people who care more about the problem than the title.
- › Own a meaningful slice of a system—from idea to architecture to v1 to scaling.

When I’m Not in Front of a Terminal
I’m a licensed skydiver with 30+ jumps. For me, skydiving isn’t about adrenaline. It’s about calm under pressure, respecting systems, and understanding where the real risks are vs. the imagined ones. That’s very similar to how I approach building companies: Don’t panic. Know your failure modes. Trust your training.
Let’s Talk
If any of this resonates and you’re working on something meaningful at the intersection of AI, infra, or hardware, I’d love to learn more and see where I can help.
Get in TouchThis website runs on
an Agentic CMS I designed
Connect your IDE, deploy AI agents, ship products. Zero to production with focus on UX, design, scalability, and maintainability.
Veloz.site
AI-native Content Management System with installable agents. Built the entire infrastructure—agent framework, coding agents, and a full Python CMS with vibe coding capabilities connectable to Cursor via CLI. From scratch.
Fuddis
Fullstack food platform for LATAM—marketplace, social network, POS, delivery, and aggregator. Led company from ideation to Techstars acceptance and $1M funding round.
Sunu
Smartwatch for blind and visually impaired. Led entire product creation 0→1: embedded design, injection moulding, assembly line, app integration. Shipped to 40+ countries worldwide.
Liberet
Nearshore software development agency. Built and managed multiple tech teams for startups. Portfolio includes Bricksell (real estate), VogueX (weddings), FileToData (AI data extraction for ERPs)—investor and advisor on multiple ventures.
Vivo Grupo Inmobiliario
Hired and trained CTO for the biggest real estate company in Cancun, Mexico
FileToData
PDF to ERP/CSV converter using AI models for data extraction and automation
Bricksell
Built initial team, hired CTO, got 5% equity, helped raise first funding round
Voguex
Wedding marketplace app for Mexico - built the mobile application
Why Work With Me?
I don't just write code; I build products that ship and sell.
EP3326604A1 — Spatial Detection Device
Ultrasound-based obstacle detection for the visually impaired
This patent covers a wearable mobility-assistance device that uses a slanted ultrasonic transducer array to detect obstacles at multiple heights. It provides tactile or audio feedback to improve independent navigation for blind or visually impaired users.
AN4245 – RCA Camera Line Detection
Basic embedded vision with MPC560xB
This NXP application note explains how to connect and use a standard RCA analog camera to perform line-detection tasks on the MPC560xB microcontroller family, enabling simple image-processing applications for robotics and autonomous systems.
AN4251 – DC & Servo Motor Control
Motor control using DSPI Automatic Serial PWM
This document provides a detailed method for controlling DC and servo motors with MPC560xB MCUs. It outlines hardware setup, PWM generation, and firmware configuration for reliable embedded motor-control implementations.
AN4244 – Line Detection with TSL1401-DB
Linescan camera integration for robotics
This note describes how to interface the Parallax TSL1401-DB linescan camera module with the MPC560xB microcontroller family to detect lines and edges. It is widely used for line-following robots and low-cost optical sensing applications.
Photography
Capturing light and moments.
Synthesizers
Making noise with voltage.
Ideal Next Role
- High Agency Environment
- Hard Tech / Deep Tech
- San Francisco / Bay Area
- Building for the Future
Core Stack
Domains
AI-Powered CV Generator
Powered by OpenAI Agents SDK
This uses an agentic workflow to create a personalized CV that highlights my most relevant experience for YOUR company.
- Shows I can build agentic AI systems
- CV tailored to your industry & needs
- Highlights only relevant experience
Complete extended CV (non-agentic)
What is your company about?
Select all relevant areas (multi-select)
Company Research
I'll analyze your company to personalize the CV
My AI agent will:
- • Research your company
- • Verify my skills match your needs
- • Or politely decline if way out of scope
Compensation Range
Help me understand the opportunity
Work Location
So I can include relevant VISA status if needed
Additional Information
Any specific requirements or must-have skills?
Optional, but helps create a more targeted CV
Crafting Your Personalized CV...
Please wait while my AI agents work their magic
Download CV
Choose your preferred format
Loading preview...
Not a Great Fit
My AI determined this might not be a match
I appreciate you checking. Feel free to reach out anyway:
cuauhtlip@gmail.com